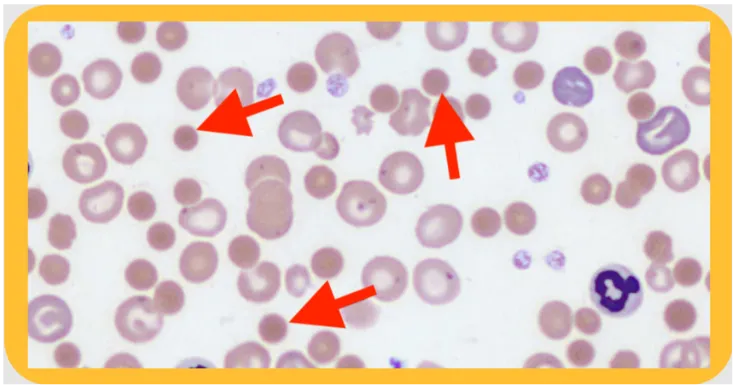
Echinocytes in pyruvate kinase deficiency blood smear

Glycolytic Defects - RBC Energy Crisis
- Red blood cells (RBCs) lack mitochondria and depend exclusively on anaerobic glycolysis for ATP production.
- Enzyme deficiencies disrupt this pathway, leading to an energy crisis (↓ ATP).
- Failure of the Na⁺/K⁺-ATPase pump causes membrane instability, dehydration, and RBC lysis.
Key Deficiencies & Features:
- Pyruvate Kinase (PK) Deficiency:
- Most common cause. Autosomal recessive.
- Causes chronic hemolytic anemia, jaundice, and splenomegaly.
- Peripheral smear shows echinocytes (burr cells).
- Glucose-Phosphate Isomerase (GPI) Deficiency: Second most common.
⭐ Despite the ATP deficit, levels of 2,3-BPG are increased, causing a rightward shift in the oxygen-hemoglobin dissociation curve, which improves oxygen delivery to tissues.
Pyruvate Kinase Deficiency - The Main Culprit
- Pathophysiology: Autosomal recessive defect in the final step of glycolysis. ↓ ATP production leads to rigid RBC membranes and subsequent extravascular hemolysis.
- Key Consequence: ↓ ATP & ↑ 2,3-bisphosphoglycerate (2,3-BPG).
- Clinical Presentation: Presents in infancy/childhood with hemolytic anemia, jaundice, and splenomegaly. Severity varies.
- Lab Findings: Normocytic anemia, reticulocytosis, and ↑ unconjugated bilirubin. ↑ 2,3-BPG levels are characteristic.
⭐ High-Yield Pearl: The accumulation of 2,3-BPG shifts the oxygen-dissociation curve to the right, facilitating O₂ delivery to tissues. This often makes the anemia less symptomatic than expected for the degree of hemolysis.
PFK-1 Deficiency - Tarui's Muscle Trouble
- Glycogen Storage Disease Type VII: An autosomal recessive disorder caused by a defect in the PFKM gene, which affects muscle and RBCs.
- Pathophysiology: Severely reduced PFK-1 activity impairs glycolysis. Muscles cannot effectively use glucose for energy, leading to glycogen accumulation.
- Clinical Features:
- Exercise intolerance: Presents as early fatigue, muscle pain, and cramps.
- Rhabdomyolysis: Can be triggered by intense exercise, leading to myoglobinuria (dark urine).
- Hemolysis: A compensated hemolytic anemia is common as RBCs depend on glycolysis.
- Diagnosis:
- Failure of blood lactate to rise after ischemic exercise.
- Elevated serum Creatine Kinase (CK).
⭐ A high-carbohydrate meal paradoxically worsens exercise intolerance by increasing the concentration of upstream glycolytic intermediates that cannot be processed.

High‑Yield Points - ⚡ Biggest Takeaways
- Pyruvate kinase deficiency, the most common defect, causes autosomal recessive hemolytic anemia as RBCs rely solely on glycolysis for ATP.
- This leads to extravascular hemolysis and splenomegaly; labs show ↑ 2,3-BPG, which shifts the O₂-dissociation curve to the right.
- Glucokinase deficiency impairs pancreatic β-cell glucose sensing, causing a stable, mild hyperglycemia known as MODY 2.
- Phosphofructokinase-1 (PFK-1) deficiency (Tarui disease) causes exercise intolerance, muscle pain, and hemolytic anemia.
Unlock the full lesson and continue reading
Signup to continue reading this lesson and unlimited access questions, flashcards, AI notes, and more